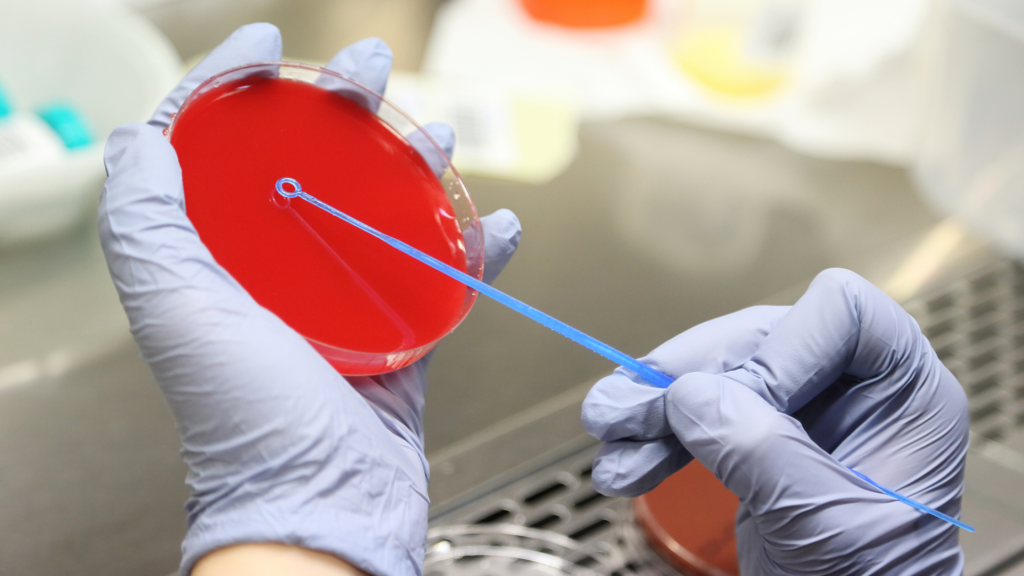
Bacterial vaginosis in pregnancy - doctor tests

The risks of bacterial vaginosis in pregnancy
The Centers for Disease Control and Prevention (CDC) estimates that 1 million women get bacterial vaginosis in pregnancy each year making it the most common cause of vaginal complaints in pregnancy. But its prevalence is low and most women are asymptomatic.
So why is it so common? This article will discuss bacterial vaginosis (BV) while pregnant and how women who are pregnant with BV treat this common pregnancy health issue. We will also talk about symptoms, treatment and disease control so you can enjoy a healthy pregnancy free from vaginal problems.

What causes Bacterial Vaginosis?
Bacterial vaginosis in pregnancy is caused by an overgrowth of the bacteria Lactobacillus and especially Gardnerella, which also play important roles in maintaining healthy vaginal flora. Bacterial vaginosis is characterised by a fishy or sour odour, frequent discharge, and a thin fluid-like yellowish film on the mucous membranes.
What is the risk of developing bacterial vaginosis during pregnancy?
The risk of developing bacterial vaginosis during pregnancy is low (at around 20%), but it is not clear how much the risk has changed now that douching is no longer recommended.
Douching is the process of intravaginal cleansing with a liquid solution to prevent or treat an infection. One study looked into the risks and benefits of douching because the act has been associated with many adverse outcomes including pelvic inflammatory disease, BV, cervical cancer, low birth weight, preterm delivery, human immunodeficiency virus transition, sexually transmitted infections, ectopic pregnancy, recurrent vulvovaginal candidiasis and infertility.
The study found that more research needs to go into whether douching is a causal factor in diseases like BV or whether it is more common among those who are at risk of STDs. Perhaps there is an increased risk of adverse effects associated with douching if certain solutions are used.
How can you lower your risk of bacterial vaginosis during pregnancy?
Bacterial vaginosis in pregnancy is the most common cause of vaginal complaints, but the complications associated with untreated BV can be serious. Therefore, it is important to understand the risk factors, symptoms, and tests for the condition. Improving hygiene, reducing stress, and making lifestyle changes are the best ways to reduce the risk of BV.
BV while pregnant – symptoms
Bacterial vaginosis in pregnancy is characterised by a fishy or sour odour, frequent discharge, and a thin fluid-like yellowish film on the mucous membranes. The most common symptom for women in bacterial vaginosis when pregnant is a vaginal odour that differs from normal vaginal discharge.
Bacterial vaginosis discharge can be described as “fishy” or “sour.” It may also have a mild to strong salty or acidic smell. Other symptoms of BV in pregnant women include increased vaginal discharge, itching and burning during urination, and pain during sex.
Tests for bacterial vaginosis in pregnancy
The diagnosis of bacterial vaginosis in pregnancy is made by a thin, watery, yellow-green or grey discharge and a fishy odour. There are several tests for bacterial vaginosis in pregnancy: wet mount, vaginal pH, Gram stain, and KOH prep.
Bacterial vaginosis in pregnancy – treatment
Treatment for bacterial vaginosis in pregnancy can be treated with antibiotics. But this treatment will depend on the severity of the symptoms and the gestational age of the foetus. In most cases, there are no adverse outcomes associated with BV during pregnancy. However, if a pregnant woman does contract bacterial vaginosis, then treatment may be necessary to prevent complications.
If you are allergic to penicillin or tetracycline antibiotics then treatment should not be administered. If you have questions about bacterial vaginosis in pregnancy, you should consult your health care provider.
Overcoming any barriers to treatment
BV is treatable, although, there can be side effects from treatment methods. Therefore, it is important to research your options before deciding on one course of treatment and consult your doctor, as some treatments may work well for others with similar symptoms, but may not work for you.
Conclusion
Bacterial vaginosis in pregnancy is the most common vaginal infection in women of childbearing age. The symptoms are often mild and may not be noticeable. However, if you are pregnant, BV can pose pregnancy complications, such as preterm birth (having the baby before your due date). Thankfully, there are steps you can take to reduce your risk.
To reduce your risk of sexually transmitted diseases, maximise your prenatal care, including only having unprotected sex with your partner who has had a negative STD screening or uses birth control that does not contain hormones, such as an IUD or a NuvaRing. If applicable, reduce the number of sex partners, to minimise STD transmission.
Triclosan soaps and douching should also be avoided. In addition, always practice good hygiene by wiping from front to back and making sure not to wear tight-fitting clothes that may trap moisture. And if you are experiencing vaginal discharge, odours, or burning during urination, see your doctor as soon as possible to get treatment for bacterial vaginosis or other possible relevant issues.
FAQ
I can’t get rid of BV during pregnancy – what do I do?
Pregnancy bacterial vaginosis can be treated with antibiotics to kill off the bacteria. The antibiotic may be oral or a cream/gel that you put into your vagina. BV antibiotics are safe for your baby during pregnancy and they may help to reduce your risk for STIs.
How do you avoid recurrent bacterial vaginosis when you are trying to conceive?
To treat bacteria in the vaginal canal which may be pregnancy BV your doctor may prefer to prescribe Oral metronidazole (Flagyl for BV in pregnancy). Intravaginal metronidazole gel or intravaginal clindamycin cream are alternatives but less preferred.
What is the diagnosis for bacterial vaginosis?
Your doctor may examine the vaginal secretions to look for ‘clue cells’ which are a sign of bacterial vaginosis in pregnancy.
What could cause BV Bacterial Vaginosis?
BV results from an imbalance of ‘good’ and ‘harmful’ bacteria in the vagina. Having multiple sex partners and not using condoms can upset the normal balance of the bacteria in the vagina, which increases the risk of getting bacterial vaginosis in pregnancy.
Can birth control cause bacterial vaginosis?
“Hormonal birth control has not been shown to cause these infections, but for some women, it can change the pH balance of the vagina and make them more prone to overgrowth of yeast or Bacterial Vaginosis (BV.) Both can cause dryness, irritation and itching.”
https://www.fpawomenshealth.com/blog/vaginal-itchingdryness-and-birth-control
Can I get a BV from my boyfriend cheating?
“Although BV can be triggered by sex, having BV is not an STI (you can still get BV even if you have not had sex) and it doesn’t mean your partner is cheating or has passed something on to you.”
https://www.hanxofficial.com/blogs/naked-truths/what-is-bacterial-vaginosis
What antibiotics women should take during pregnancy?
The following antibiotics can be taken by pregnant women:
- Penicillins, including amoxicillin (Amoxil, Larotid) and ampicillin.
- Cephalosporins, including cefaclor and cephalexin (Keflex)
- Clindamycin (Cleocin, Clinda-Derm, Clindagel)
Can men carry bacteria that infect women with bacterial vaginosis after they have been treated with antibiotics?
Men can’t get BV because the penis doesn’t contain the same delicate balance of bacteria, but they can pass on bacteria which can cause bacterial vaginosis in pregnancy because of a change in the vaginal bacteria balance and/or exposure to a new sexual partner.
I had an IUD inserted 3 weeks ago and my vagina has had an odour in the past week. Could there be something more going on than just the IUD?
“An IUD should never cause a weird smell, itching, redness, or other irritation. These are all signs of infection and should be checked out asap.”
https://www.fpawomenshealth.com/blog/topic-tuesday-vaginal-odor
Is bacterial vaginosis and a friable cervix that bleeds because of inflammation a sign for cervical cancer?
Friable means easily irritated, which makes the cervix prone to inflammation, bleeding, or tearing. BV can affect the cervix. It’s possible that BV and a friable cervix can clear up on their own, but if left untreated, it could lead to other health issues like infertility and possibly cervical cancer. If you have BV and a friable cervix, you should visit your doctor immediately for an accurate diagnosis and treatment.
What’s the best treatment for recurrent bacterial vaginosis BV?
“Antibiotics for bacterial vaginosis. Oral antibiotics are the first-choice treatment in pregnant women with BV. A full course of metronidazole tablets is the common treatment. Metronidazole is an antibiotic.”
https://patient.info/sexual-health/vaginal-discharge-female-discharge/treating-and-preventing-bacterial-vaginosis
Why would bacterial vaginosis symptoms persist through antibiotic treatment when doctors say I’m clear then later recur?
“Around a third of women who take antibiotic treatment for bacterial vaginosis (BV) find that the problem recurs within the next two to three months. Some strains of BV organisms may have resistance to some antibiotics. You should return to your healthcare provider and describe the problems you are having.”
https://www.thebody.com/article/what-should-i-do-if-antibiotics-did-not-clear-up-m
Can the antibiotics of sulfamethoxazole treat bacterial vaginosis?
“Trimethoprim-sulfamethoxazole should be avoided, if possible, during the first trimester of pregnancy because of the antifolate effect associated with neural tube defects.”
https://www.ncbi.nlm.nih.gov/pmc/articles/PMC2426978/
What are the signs and symptoms of bacterial vaginosis?
Bacterial vaginosis in pregnancy signs include:
- thin, grey, white or green vaginal discharge
- foul-smelling ‘fishy’ vaginal odour
- vaginal itching
- burning during urination
How do I cure vaginal bacterial infections naturally without antibiotics?
Most women with BV can have a normal pregnancy and up to half of the cases resolve on their own. however, studies still show that having BV while pregnancy can increase the risk of preterm birth and having a low birth weight baby. There are some home remedies to treat BV but antibiotics can treat most cases. These are:
- Use barrier protection when having sex
- Urinating immediately after intercourse
- Avoid scented vaginal products
- Abstain from douching
- Washing the vagina regularly
- Wear breathable cotton underwear
- Keep the vaginal area dry
- Wash your hands before you touch your vagina
- Taking probiotics like yoghurt, fermented foods, some cottage cheese and kefir
- Garlic supplements
Please check with your doctor trying the above during pregnancy.
Can one treat bacterial vaginosis with dicloxacillin?
Dicloxacillin is a penicillin-type antibiotic and is used to treat a wide variety of bacterial infections. Dicloxacillin has been assigned to pregnancy category B by the FDA. It should only be given when need has been clearly established as there has been no controlled data relating to its use in pregnancies. Therefore, it is not recommended during pregnancy because it can affect tooth and bone development in your baby. Talk to your doctor about taking a different antibiotic for bacterial vaginosis.
How efficient are boric acid suppositories for treating bacterial vaginosis?
Please note Boric acid should not be taken during pregnancy and is toxic to the developing foetus.
“The cure rates with boric acid ranged from 40 to 100 percent.
This review, however, did not specifically focus on the bacteria that causes BV.
While these results are encouraging, more studies need to be done to confirm that boric acid is, in fact, an effective add-on treatment for BV.”
https://www.healthline.com/health/womens-health/can-boric-acid-help-treat-bacterial-vaginosis#safety
How should I take antibiotics to cure bacterial vaginosis?
A bacterial infection during pregnancy can be treated with antibiotic tablets or gels/creams to prevent preterm labour and ultimately premature birth.
Consult a medical professional for more information on BV in pregnancy and do not rely on the information in this article to diagnose yourself or someone else with BV.
*Collaborative feature post*








